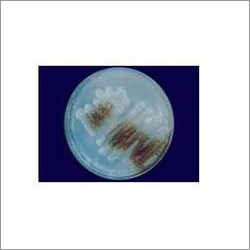

Nitro Samrudhhi Azotobacter For Fruits And Vegetables Application: Agriculture
Price:
Get Latest Price
Minimum Order Quantity :
100 Pack
In Stock
Product Specifications
| Physical State | Powder |
| Release Type | Controlled |
| Purity(%) | 100% |
| Application | Agriculture |
| Storage | Room Tempertaure |
| Payment Terms | Cash on Delivery (COD) |
| Supply Ability | 5000 Per Month |
| Delivery Time | 10 Days |
| Main Domestic Market | All India |
Company Details
Altret is leading and most trusted brand in Biological Products in World. Altret has very strong R&D centre at Surat and Ahmedabad to provide cutting edge solutions to Farming needs in sustainable way. Strong QC standard and policy makes altret to provide best quality produce to Farming Community of world.
Business Type
Exporter, Manufacturer, Supplier
Employee Count
37
Establishment
2006
Working Days
Monday To Sunday
GST NO
24AAFCA9180P1Z5
Payment Mode
Cash Advance (CA), Cash in Advance (CID), Cheque, Letter of Credit (L/C), Telegraphic Transfer (T/T)
Certification
ISO 9001, ECOCERT
Related Products
Explore Related Categories
More Product From This seller
Seller Details
GST - 24AAFCA9180P1Z5
Ahmedabad, Gujarat
Support Executive
Mr Altret Biotech
Members since
5 Years
Address
34 - SF, 4D Square Mall, Near Vishwakarma Engineering College, Motera, Ahmedabad, Gujarat, 380005, India
azotobacter in Ahmedabad
Report incorrect details